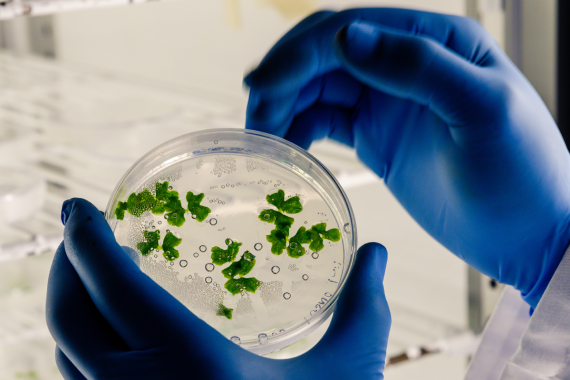

In-line Homogenizer

An inline homogenizer is a high-performance mixing device designed to create fine emulsions, dispersions, & suspensions through intense shear forces. It supports continuous processing, making it ideal for large-scale production. With a versatile design, it suits various applications across industries like food, pharmaceuticals, & chemicals. The equipment is scalable, hygienically constructed with stainless steel, & energy-efficient, ensuring cost-effective & contamination-free operation.
Features
- High shear mixing achieves fine emulsions & dispersions through intense shear forces.
- Continuous processing allows for uninterrupted production, enhancing efficiency.
- Versatile design suitable for various applications across different industries.
- Scalability is easily adjustable for both small-scale & large-scale production.
- Hygienic construction built with stainless steel for easy cleaning & contamination prevention.
- Energy efficiency minimizes power consumption, reducing operational costs.

InterTech’s In-line Homogenizer is engineered for seamless, continuous homogenization of liquids and semi-solids, perfect for food, pharmaceutical, and chemical production lines. We offer customized designs to match your flow rates, material viscosities, and process integration needs.
Precision Mixing for Streamlined Operations
InterTech’s In-line Homogenizer delivers precise and efficient mixing directly within your pipeline, ideal for cosmetic, biotech, and food processing industries. We tailor solutions to your specific throughput, pressure requirements, and material characteristics.
InterTech’s standard models provide:
- High-shear rotor-stator for instant emulsification.
- Consistent output with no batch variability.
- Hygienic SS 316/SS 304 construction for easy sanitation.
- Compact design for integration into existing pipelines.
- Optional multi-stage heads for enhanced particle reduction
- Flow Rate: 50L/h to 20,000L/h (customizable)
- Material Construction: SS 316/SS 304
- Motor Power: 2.2 kW to 45 kW
- Operating Speed: Up to 3600 RPM (adjustable)
- Connection Type: Tri-clamp or flanged Control
- System: Variable frequency drive (VFD) with PLC option
- Applications: Sauces, lotions, syrups, polymer dispersions
Boost your production line efficiency with InterTech’s In-line Homogenizer!
Applications
- Pharmaceutical
- Beverages
- Cosmetic
- Biotechnology
- Nanotechnology

Related Products
Your Process. Our Precision.
Partner with Intertech for scalability & compliance trusted by the global leaders.






